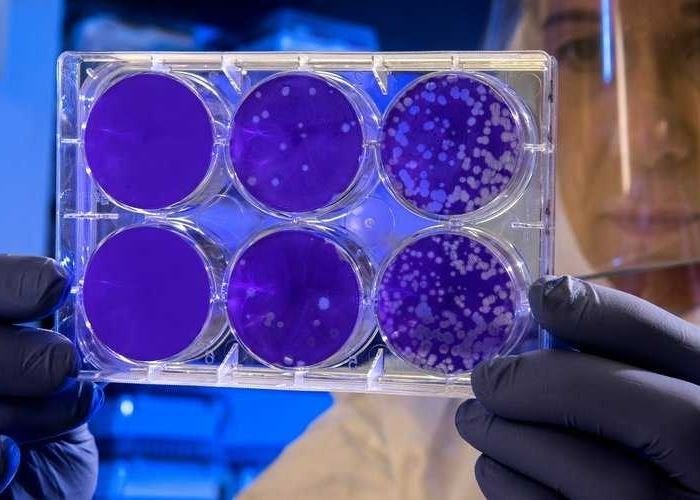

منبر العراق الحر : تعتبر أمراض القلب والأوعية الدموية السبب الرئيسي للوفيات في العالم، و يلاحظ ارتفاع نسبة الوفاة بسبب احتشاء عضلة القلب والجلطة الدماغية بين الرجال الذين هم دون 40 عاما. وتوضح الدكتورة يكاتيرينا كاشوخ، الخبيرة في مختبر Hemotest، أسباب هذه الظاهرة، وكذلك كيفية الحماية من الأمراض الخطيرة. وتقول، …
أقرأ المزيدالعلماء يعلنون عن عقار “ثوري” يمكن أن “يعالج” سرطانا عدوانيا
منبر العراق الحر : أبلغ العلماء عن اختراق علمي “مثير”، يبدو أنه سيكون أحد أكثر أنواع السرطان عدوانية، أكثر قابلية للعلاج. ويميل المرضى المصابون بالورم الأرومي الدبقي، وهو نوع سريع النمو من السرطان يصيب الدماغ والحبل الشوكي، إلى البقاء على قيد الحياة لمدة 15 شهرا فقط من لحظة التشخيص. وفي …
أقرأ المزيدفوائد ومضار عسل النحل على الصحة
منبر العراق الحر : أعلنت الدكتورة إيرينا أيسترينا، أخصائية أمراض المناعة والحساسية، أن عسل النحل قد يشكل خطورة على حياة المرضى الذين يعانون من اضطراب عملية التمثيل الغذائي ومرض السكري. وتشير الأخصائية في حديث لصحيفة “إزفيستيا”، إلى أن الكثيرين في فصل الخريف يفكرون في كيفية تعزيز منظومة المناعة، ومعظمهم يعتقد …
أقرأ المزيدفوائد أخرى “للفياغرا”!
منبر العراق الحر : يشتهر دواء السيلدينافيل – المعروف باسم العلامة التجارية الفياغرا – بعلاجه ضعف الانتصاب عند الذكور، إلا أن له، في الواقع، أغراضا طبية أخرى. ووفقا للخبراء، فإنه يمكن استخدام السيلدينافيل لعلاج أمراض الرئة، التي غالبا ما يكون لها توقعات سيئة. ويعمل السيلدينافيل عن طريق تثبيط إنزيم يسمى …
أقرأ المزيدلماذا تعاني النساء الحوامل من أمراض الأسنان؟
منبر العراق الحر : أعلن طبيب الأسنان الروسي سيرغي كوفالتشوك، أن أسنان المرأة أثناء فترة الحمل أو بعد وضع الجنين مباشرة تصاب بأمراض وتتهشم أسنانها بسبب نقص الكالسيوم والفلور في جسمها. ويقول كوفالتشوك، “عمليا تستخدم جميع العناصر المعدنية التي تدخل إلى جسم المرأة الحامل، في عملية نمو الجنين، ونتيجة لذلك …
أقرأ المزيددراسة: البوتوكس لا يمنع التجاعيد فقط بل يمكنه “القضاء على اضطراب عقلي” مقلق
منبر العراق الحر : يعرف البوتوكس بخصائصه التي تعمل على القضاء على التجاعيد. لكن الباحثين يعتقدون أن الحقن قد تكون لها فائدة أخرى، وهي درء الكآبة. ويعتقد الباحثون الألمان أن البوتوكس قد يساعد المرضى الذين يعانون من اضطراب الشخصية الحدية، والذين غالبا ما يعانون من الاكتئاب. ويُعد اضطراب الشخصية الحدية …
أقرأ المزيدالكشف عن أفضل بدائل السكر
منبر العراق الحر : كشفت الدكتورة زهرة بافلوفا، أخصائية الغدد الصماء، ما هي أفضل بدائل السكر وتشير الأخصائية الروسية في موقعها بشبكة Telegram، إلى أنه من الأفضل استبدال السكر بنبات ستيفيا السكري، حيث أن مستوى حلاوة مستخلص هذا النبات أعلى من السكر التقليدي ولا يحتوي على سعرات حرارية. وتضيف، لا …
أقرأ المزيدالعربة المريخية ” Zhurong” تعثر على آثار فيضانات دورية في سهول المريخ
منبر العراق الحر : اكتشفت العربة المريخية الصينية ” Zhurong” في باطن كوكب المريخ طبقات من الصخور الرسوبية. تشير إلى حدوث فيضانات دورية على سهوله. وتشير مجلة Nature، إلى أن العربة الصينية “Zhurong” حصلت على معلومات عن تركيب طبقات الصخور الرسوبية في باطن المريخ بمنطقة سهل يوتوبيا، التي نشأت نتيجة …
أقرأ المزيدالفيروسات تستغل قدرتها على الإحساس بالبيئة لتقرير “التكاثر والقتل”
منبر العراق الحر : وجدت دراسة أن الفيروسات تستخدم المعلومات من بيئتها “لتقرير” متى تجلس بإحكام داخل مضيفها ومتى تتكاثر وتنفجر، ما يؤدي إلى قتل الخلية المضيفة. وتقترح الدراسة بقيادة جامعة ماريلاند في مقاطعة بالتيمور (UMBC) في مؤسسة Frontiers in Microbiology أن هذا العمل يضيف مجموعة جديدة من التعقيدات إلى …
أقرأ المزيدثلاث مجموعات غذائية يمكن أن تضيف “أكثر من عقد” إلى العمر الافتراضي للفرد
منبر العراق الحر : عندما يتعلق الأمر بالعمر المديد، فإنه لا توجد وصفة سحرية يمكن أن تزيد من طول العمر بين عشية وضحاها. ولأن التقدم في العمر يمكن أن يحمل بعض المخاطر الصحية المقلقة، والتي يمكن أن تؤثر على طول العمر الافتراضي، فإن التغلب على هذه العقبات قد يساعد على …
أقرأ المزيد منبر العراق الحر منبر العراق الحر
منبر العراق الحر منبر العراق الحر